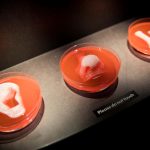
A fascinatingly grisly guide to replacing and repairing body parts

Located in the Potrero Hill neighborhood of San Francisco, the Catherine Clark Gallery houses a unique exhibit that has recently garnered attention. Tucked away in a back room of the gallery is a 2,000-pound replica of the White House, created by sculptor Al Farrow in 2018. This remarkable piece, titled “White House,” is made from repurposed bullets, gun parts, shell casings, and glass, giving it a striking and thought-provoking appearance.
The sculpture, measuring over six feet wide, is currently on display at the Catherine Clark Gallery with a price tag of $500,000. Despite being created a few years ago and previously featured in museum exhibitions, “White House” has been brought back into the spotlight for the Fall of Freedom series of art and protest actions taking place nationwide. Farrow himself spoke at the gallery during a special viewing event on November 21, emphasizing the renewed significance of the piece in the current political climate.
According to Farrow, the idea for “White House” originally came to him during George W. Bush’s presidency, but it was put on hold when Barack Obama was elected in 2008. With the rise of Donald Trump in 2016, Farrow revisited the concept and brought it to fruition. Unlike many of his other sculptures, which focus on religious iconography and the connection between religion and violence, “White House” marks a thematic departure for Farrow.
One striking aspect of the sculpture is its cylindrical form, which is composed of bullets and gun barrels. Farrow intentionally chose to base the dimensions of the White House replica on machine gun barrels, creating a powerful visual statement. The rusted appearance of the sculpture symbolizes the corrosion and degeneration of the presidency in the artist’s eyes, particularly under the Trump administration.
Throughout his career, Farrow has been known for using gun parts in his artwork to provide social commentary and critique. His sculptures often challenge viewers to reflect on issues of violence, power, and authority. In light of recent changes to gun laws and regulations, Farrow’s work takes on added relevance and serves as a poignant reminder of the impact of firearms on society.
Despite the challenges and uncertainties of the current political climate, Farrow remains dedicated to his art. At 80 years old, he continues to create thought-provoking pieces that spark conversation and reflection. His latest sculpture, inspired by the Violins of Hope project, showcases his ongoing commitment to using art as a means of expression and social commentary.
As “White House” continues to captivate audiences at the Catherine Clark Gallery, Farrow’s work serves as a powerful reminder of the role of art in challenging and questioning the status quo. Through his unique use of materials and provocative themes, Farrow invites viewers to engage with complex issues and consider the impact of political decisions on society as a whole.